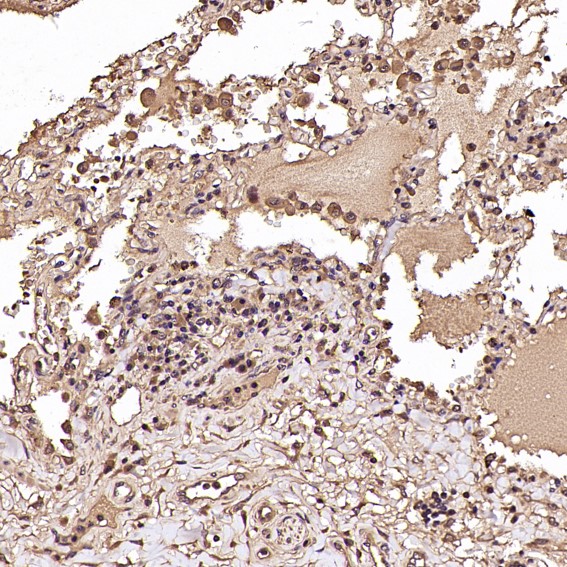

Rabbit Monoclonal to NAK/TBK1(N-term)
货号:
P17065
别名:
NAK; T2K; NF-kappa-B-activating kinase; TANK-binding kinase 1; Serine/threonine-protein kinase TBK1; T2K; TANK binding kinase 1;;TBK1
应用:
WB,IHC/IHF,IF,
反应种属:
Human,Mouse,Rat
抗体类型:
Primary antibody
Swissprot:
Q9UHD2
规格:
目录价
在线咨询
Description |
|---|
Serine/threonine kinase that plays an essential role in regulating inflammatory responses to foreign agents.Following activation of toll-like receptors by viral or bacterial components, associates with TRAF3 and TANK and phosphorylates interferon regulatory factors (IRFs) IRF3 and IRF7 as well as DDX3X. |
Specification |
|
|---|---|
| Aliases | NAK; T2K; NF-kappa-B-activating kinase; TANK-binding kinase 1; Serine/threonine-protein kinase TBK1; T2K; TANK binding kinase 1;;TBK1 |
| Swissprot | Q9UHD2 |
| WB Predicted band size | 84 kDa |
| Host/Isotype | Rabbit IgG |
| Antibody Type | Primary antibody |
| Storage | Store at 4°C short term. Aliquot and store at -20°C long term. Avoid freeze/thaw cycles. |
| Species Reactivity | Human,Mouse,Rat |
| Immunogen | A synthesized peptide derived from human TBK1 |
| Formulation | Purified antibody in PBS with 0.05% sodium azide,0.05% BSA and 50% glycerol. |
Application |
|
|---|---|
| WB | 1/1000-1/2000 |
| IHC | IHC:1/100-1/200;IHF:1/50-1/200 |
| IF | 1/50-1/200 |
Product Image
-
All lanes use the Antibody at 1:2K dilution for 1 hour at room temperature.

-
All lanes use the Antibody at 1:2K dilution for 1 hour at room temperature.

-
All lanes use the Antibody at 1:2K dilution for 1 hour at room temperature.

-
Western blot analysis of NAK/TBK1 expression in HeLa cell lysate.

-
Immunohistochemical analysis of paraffin-embedded Rat liver, using the Antibody at 1:100 dilution.

-
Immunohistochemical analysis of paraffin-embedded Rat stomach, using the Antibody at 1:100 dilution.

-
Immunohistochemical analysis of paraffin-embedded Human lung, using the Antibody at 1:100 dilution.

-
Immunohistochemical analysis of paraffin-embedded Human colon cancer, using the Antibody at 1:100 dilution.

-
Immunohistochemical analysis of paraffin-embedded Mouse skin, using the Antibody at 1:100 dilution.

-
Immunohistochemical analysis of paraffin-embedded human testis, using NAK/TBK1 (N-term) Antibody.

鄂公网安备42018502007531号

